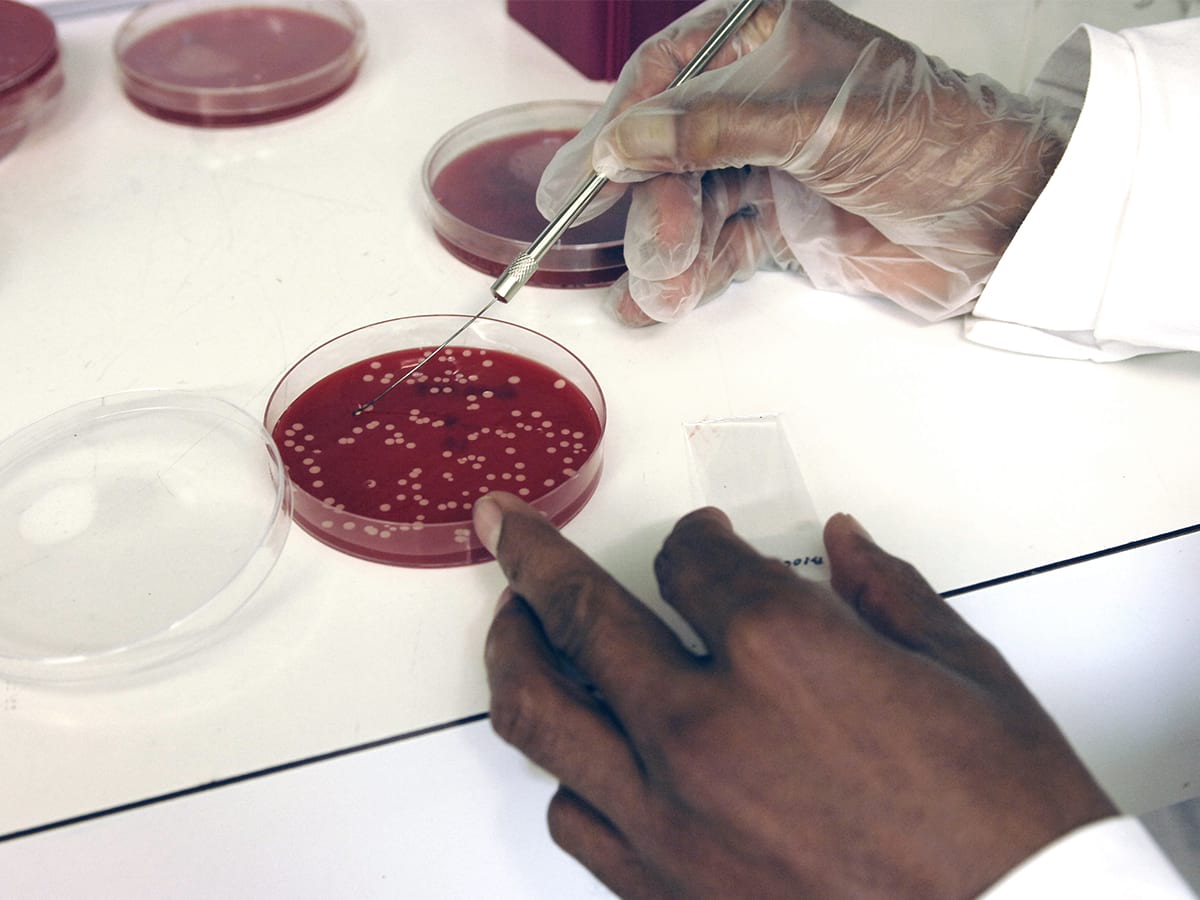

24.10.2025
Die Wissenschaft retten, die wir dringend brauchen
Durch falsche und nicht reproduzierbare Forschungsergebnisse sowie durch woke Einflüsse leidet die Wissenschaft. Wir brauchen mehr Transparenz und eine Rückkehr zur Wahrheitssuche.
Die Krise der Wissenschaft, die die Forschung untergräbt, wird weithin unterschätzt – vor allem, weil irreproduzierbare Ergebnisse, ideologische Voreingenommenheit, Interessenkonflikte und Betrug meist isoliert diskutiert werden, ohne ihre gemeinsamen Ursachen und kumulativen Auswirkungen zu erkennen. Wissenschaftler allein können dieses Problem nicht lösen. Eine kritische Bürgerbeteiligung ist unerlässlich. Doch zuvor muss die Öffentlichkeit informiert werden.
Betrug ist naturgemäss schwer fassbar. Verbesserte Erkennungsmethoden (z. B. Bildduplikationsanalysen) liefern dennoch wertvolle Einblicke in vergangenes Fehlverhalten. Besonders beunruhigend ist, dass Betrug nicht mehr nur von Einzelpersonen begangen wird, sondern zunehmend von organisierten Netzwerken getragen wird.
Bereits 2005 zeigte John Ioannidis in seinem bahnbrechenden Artikel „Why Most Published Research Findings Are False“, dass die meisten veröffentlichten Forschungsergebnisse falsch sind. Ein groß angelegtes Replikationsprojekt in der Psychologie bestätigte, dass nur eine Minderheit der Ergebnisse reproduzierbar ist. Auch in der Onkologie und biomedizinischen Forschung sind die Replikationsraten erschreckend niedrig. Ein Grund dafür ist der Publikationsbias: Spektakuläre Ergebnisse werden eher veröffentlicht, obwohl sie häufiger statistische Ausreißer sind.
Diese Krise könnte deutlich verringert werden durch die vollständige Offenlegung von Daten und Methodik, die Vorabregistrierung von Hypothesen sowie die Annahme wissenschaftlicher Arbeiten durch Fachzeitschriften auf Grundlage der Relevanz der Fragestellung und der methodischen Strenge – nicht aufgrund der Ergebnisse. Universitäten sollten mehr Replikationsstudien durchführen, und Medien sollten den Replikationsstatus systematisch kommunizieren.
„Wokeismus kann nicht nur Forscher zum Rücktritt zwingen oder die Anstellung inkompetenter Personen erzwingen, sondern auch Forschungs- und Lehrinhalte vorschreiben.“
Ermutigend ist die wachsende Zahl von Initiativen wie das Center for Open Science oder das Institute for Replication. Doch ihr Einfluss bleibt bescheiden im Vergleich zur Größe der Krise. Die Replikationskrise ist seit Jahren bekannt, bleibt aber trotz vorhandener Lösungen weitgehend ungelöst. Liegt es an reiner Trägheit?
Das tiefere Problem liegt darin, dass für zu viele Wissenschaftler die Wahrheitsfindung nicht mehr die oberste Priorität ist. Dies zeigt sich deutlich in ihrer zunehmenden Unterwerfung unter autoritäre Ideologien.
Große Universitäten, besonders in den USA, sind von autoritären Ideologien vereinnahmt worden. Um diesen ideologischen Griff aufzudecken, gelang es Peter Boghossian, James Lindsay und Helen Pluckrose, bewusst absurde, aber politisch korrekte Artikel zu veröffentlichen (sie präsentieren ihre Arbeit in einem Video). Aufgrund seiner kritischen Haltung gegenüber dem Wokeismus wurde Boghossian – wie andere aus der akademischen Forschung, z. B. Jordan Peterson und Bret Weinstein – zum Rücktritt gedrängt. Die Belästigung von Personen, die als politisch inkorrekt gelten, entsteht oft durch gemeinsames Lobbying bestimmter Studenten, Verwaltungsmitarbeiter und Wissenschaftler. Der Wokeismus kann nicht nur Forscher zum Rücktritt zwingen oder die Anstellung inkompetenter Personen erzwingen, sondern auch Forschungs- und Lehrinhalte vorschreiben oder verbieten sowie die Art und Weise verzerren, wie diese Themen untersucht werden. Der konservative Aktivist Charlie Kirk versuchte, ideologische Vielfalt auf Universitätscampussen zu fördern, indem er Debatten unter dem Motto „Prove me wrong“ („Beweise, dass ich Unrecht habe“) organisierte, bei denen alle eingeladen waren, mit ihm zu debattieren. Am 10. September 2025 wurde Kirk während einer solchen öffentlichen Veranstaltung an der Utah Valley University ermordet.
Innerhalb der wissenschaftlichen Gemeinschaft regt sich Widerstand. Eine Vielzahl akademischer Stimmen erhebt sich etwa in The War on Science, herausgegeben von Lawrence Krauss. Unklar bleibt, ob die am stärksten vereinnahmten Universitäten wiederhergestellt oder durch neue, gesündere Institutionen ersetzt werden müssen.
„Die Covid-19-Pandemie ist keineswegs das einzige Beispiel, in dem Interessenkonflikte eine Rolle spielen.“
Eine Korrektur des ideologischen Griffs auf US-Universitäten ist längst überfällig. Doch der Ansatz der aktuellen Trump-Administration ist grob und undifferenziert. Er stellt keine Wiederherstellung des Gleichgewichts dar, sondern das Aufkommen eines rechten Autoritarismus, der die Exzesse des Wokeismus spiegelt. Zwei Autoritarismen, die sich gegenseitig verstärken. Die Wissenschaft in den USA steckt zwischen ihnen fest.
Die ideologische Vereinnahmung ist in Nordamerika am stärksten, breitet sich aber auch in Europa aus (vgl. etwa Frankreich). Angesichts der globalen Natur der Wissenschaft wirken sich voreingenommene Ergebnisse amerikanischer Universitäten jedoch weltweit auf ganze Disziplinen aus – zumal viele der renommiertesten Institutionen in Nordamerika angesiedelt sind und ideologisch vereinnahmt wurden.
Einige Forscher stellen persönliche Vorteile auf besonders krasse Weise über die Wahrheit. So veröffentlichten 27 Wissenschaftler einen Brief im Lancet, in dem sie jene, die einen möglichen Laborursprung von Covid-19 andeuteten, als „Verschwörungstheoretiker“ diffamierten – und so die Debatte in der frühen Phase der Pandemie unterdrückten. Mehrere Autoren verschwiegen dabei Interessenkonflikte, insbesondere Peter Daszak, der mit dem Wuhan Institute of Virology zusammengearbeitet hatte. Während der Covid-19-Pandemie erstreckten sich Zensur und Diffamierung Andersdenkender nicht nur auf den Ursprung des Virus, sondern auch auf Wirksamkeit und Nebenwirkungen der getroffenen Maßnahmen – sei es Lockdowns, Maskenpflicht, Impfungen, Medikamente usw.
Die Covid-19-Pandemie ist keineswegs das einzige Beispiel, in dem Interessenkonflikte eine Rolle spielen. Diese entstehen oft durch private Finanzierung. Geldgeber können Forscher beeinflussen oder schlicht jene auswählen, die mit grösserer Wahrscheinlichkeit die gewünschten Ergebnisse liefern. Fakten sprechen meist nicht für sich selbst. Eine Studie gab verschiedenen Forschern identische Daten, um zwei Hypothesen zu testen – ihre Schlussfolgerungen unterschieden sich stark. Es reicht also oft schon, den „richtigen“ Analytiker zu wählen, um das gewünschte Resultat zu erhalten. Forscher können Daten oft so interpretieren, dass sie ihre ideologischen, finanziellen oder karrierebezogenen Ziele unterstützen.
„Die Wissenschaft genießt noch Prestige aufgrund vergangener Errungenschaften.“
Die Krise der Wissenschaft hat viele Facetten, aber eine gemeinsame Wurzel: Die Wahrheit wird oft hintangestellt. Zwar arbeiten viele Wissenschaftler weiterhin sorgfältig und nach höchsten Standards, doch immer mehr stellen andere Ziele über die Wahrheitsfindung. Diese sind keine echten Wissenschaftler mehr. Dennoch brauchen wir die Wissenschaft dringend, um große Herausforderungen zu bewältigen. Aber sie kann diese Rolle nur erfüllen, wenn sie wiederhergestellt wird. Die Wahrheitsfindung muss wieder ihr zentraler Wert sein. Wissenschaftliche Methode und Meinungsfreiheit müssen zurückkehren.
Die Wissenschaft genießt noch Prestige aufgrund vergangener Errungenschaften. Unsere technologische Macht zeigt, dass wir etwas über die Funktionsweise der Welt verstanden haben. Doch diese Erfolge der Vergangenheit sagen nichts über den heutigen Zustand der Wissenschaft aus – und schon gar nicht über Disziplinen, die nicht zur Technologie führen. Vertrauen muss je nach Disziplin und Institution variieren. Es geht nicht darum, alles, was sich „Wissenschaft“ nennt, pauschal zu glauben oder abzulehnen, sondern Vertrauen dem Grad wissenschaftlicher Strenge entsprechend zu gewähren. Wenn jene, die die wissenschaftliche Methode verraten, erkennen, dass sie die öffentliche Meinung nicht länger beeinflussen können, werden sie unter Druck geraten, sich zu ändern.
Wissenschaftler werden die Wissenschaft nicht selbst retten, es sei denn, die Bürger – die einen Großteil ihrer Forschung finanzieren und entscheiden können, sich nicht länger von unwissenschaftlichen Studien täuschen zu lassen – zwingen sie zum Handeln. Bürger müssen informiert werden. Laut einer Studie haben 75 Prozent der Deutschen noch nie von der Replikationskrise gehört. Vielleicht sollte der Hinweis „Die meisten veröffentlichten Forschungsergebnisse sind falsch“ auf jeder wissenschaftlichen Arbeit stehen – bis ein verlässlicher, ideologisch neutraler Index wissenschaftlicher Strenge nach Disziplin und Institution etabliert ist. Das würde die wissenschaftliche Gemeinschaft zur Selbstreinigung motivieren.
Die Tiefe der Krise kann schwindelerregend wirken und in den Nihilismus führen. Doch wir haben einen Kompass: Die wissenschaftliche Methode funktioniert, um der Wahrheit näherzukommen. Das Problem ist, dass „Wissenschaftler“ sie allzu oft aufgeben. Wir wissen, was zu tun ist. Und wir können Disziplinen und Institutionen vertrauen, die die wissenschaftliche Methode konsequent anwenden. Bürger, Journalisten und Wissenschaftler müssen jetzt handeln, um die Seele der Wissenschaft wiederherzustellen: die kompromisslose Suche nach Wahrheit.